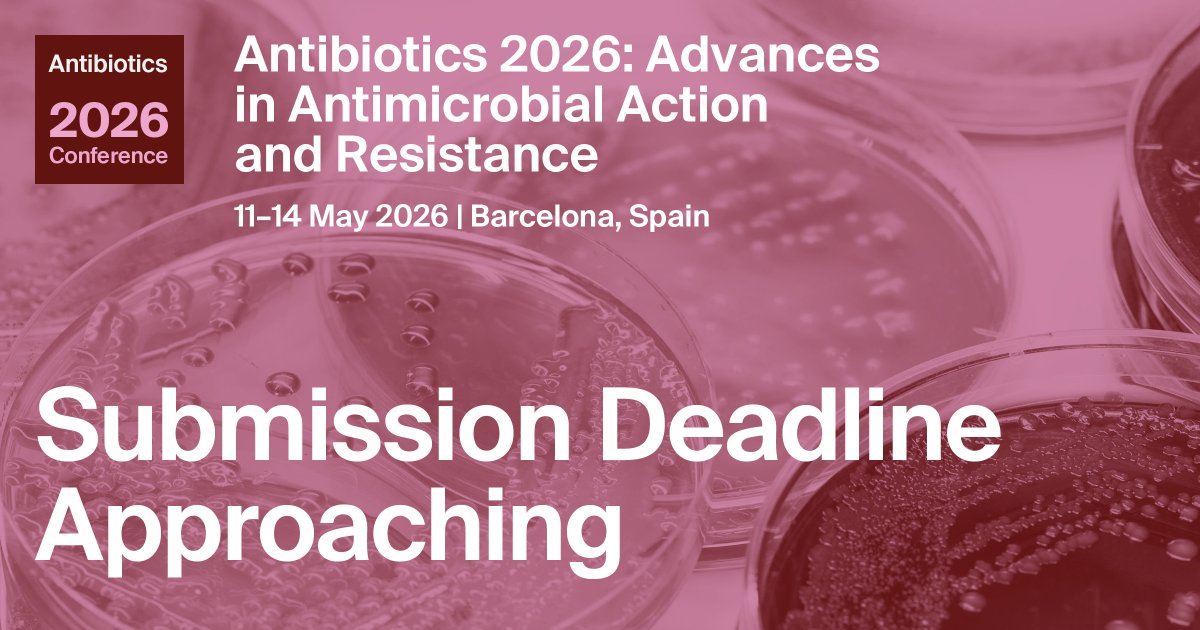
MDPI Sciforum - Conferences tweet media
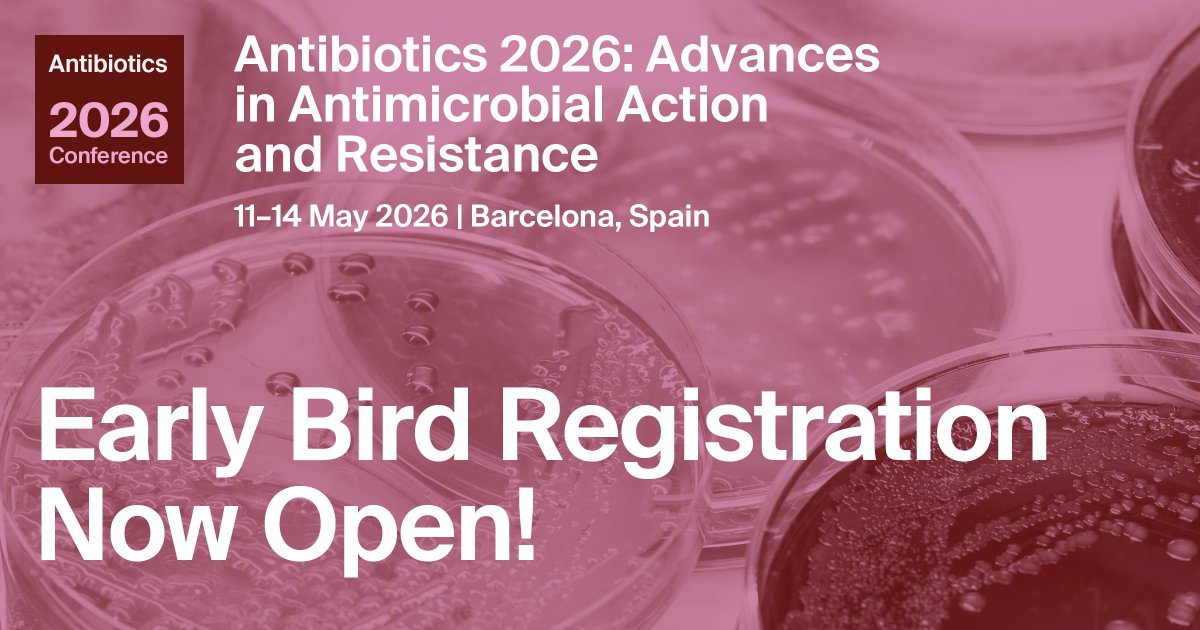
MDPI Sciforum - Conferences tweet media
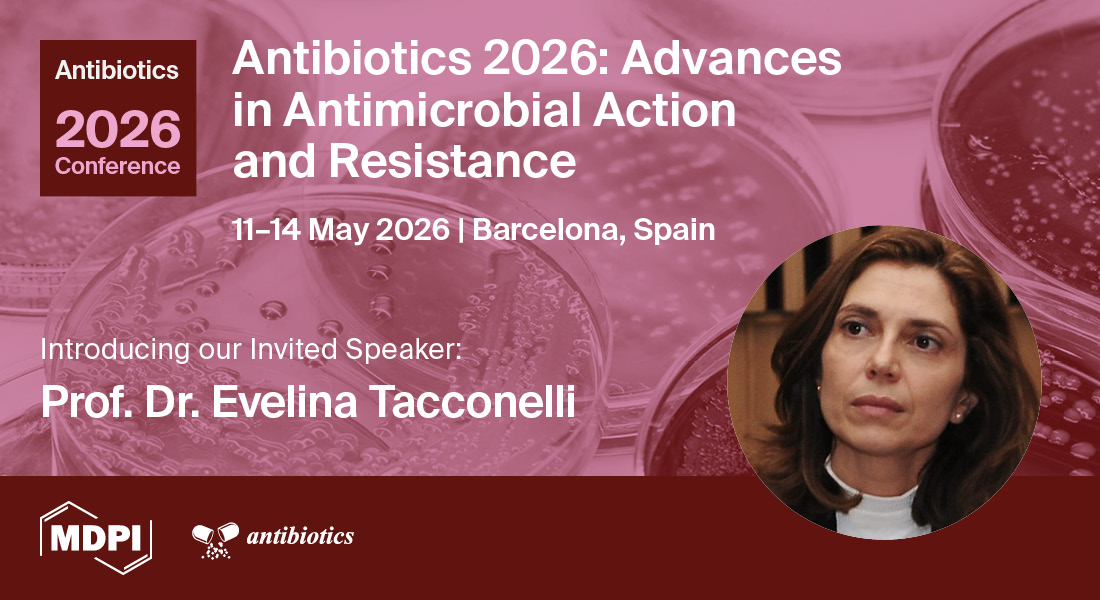
MDPI Sciforum - Conferences tweet media

Very proud and honored to be part of this excellent article directed by Dr Antonietta Cultrone and published in Gut Microbes
tandfonline.com/doi/full/10.10…
English
Marc Maresca
106 posts


@MarescaMarc
Enseignant-Chercheur - ISM2 - Campus de Saint Jérôme - Aix Marseille Université